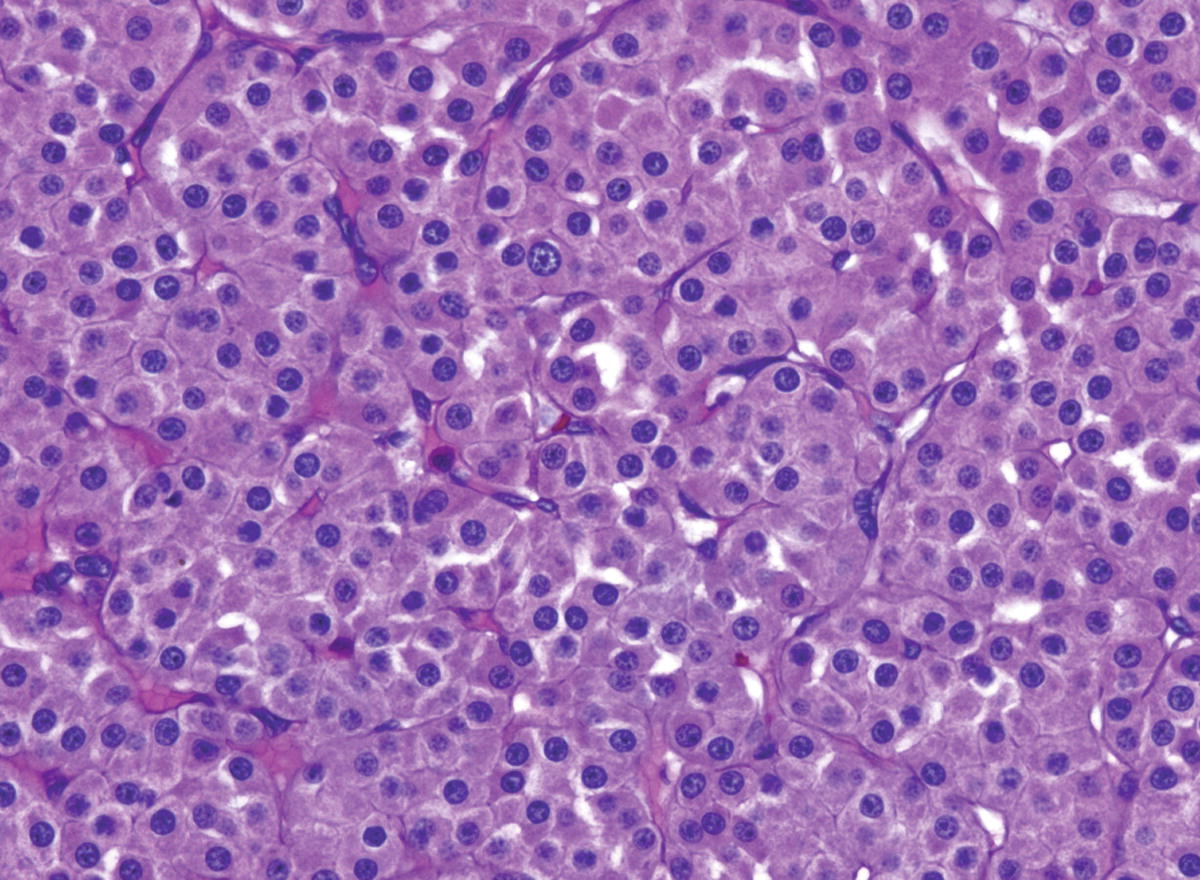
Kidney Springerlink

Congenital Mesoblastic Nephroma Pathology Outlines
May involve renal sinus.

Congenital mesoblastic nephroma pathology outlines. Cytogenetic and molecular relationship to congenital infantile fibrosarcoma. Unilateral extensive sampling of margin should be performed classic. Cystic nephroma has not been described either in the antenatal or neonatal periods which should help to differentiate it from other tumors such as cystic mesoblastic nephroma 19. Kidney tumor congenital mesoblastic nephroma.
However a readily identifiable subset of these kidney tumors has a more malignant potential and is capable of causing life threatening. Mean 5 cm variably circumscribed white yellow whorled mass near hilum involving over half of kidney with indistinct tumor kidney interface. Hemorrhage and necrosis uncommon. Epithelial predominant triphasic tumor with undifferentiated blastema back to top.
Congenital mesoblastic nephroma t1215 is associated with etv6 ntrk3 gene fusion. Congenital myofibroblastic tumor with collagen. The recurrence rate varies from 5 to 50. Epidemiology it is the commonest neonatal renal t.
Irregular infiltrating edges wilms tumor. Resembles leiomyoma with whorled cut surface. Kidney pathology pathology in outline format with mouse over histology previews. Congenital mesoblastic nephroma although rare is the most common renal neoplasm in the first months of life.
On ct images visualizing the symmetric excretion of contrast material by the remaining functioning renal parenchyma helps to differentiate mcrt from multicystic dysplastic kidney. This neoplasm is generally non aggressive and amenable to surgical removal. In rare cases the tumor may be seen in the kidneys a condition known as cellular congenital mesoblastic nephroma cmn surgically excised tumors are known to return.